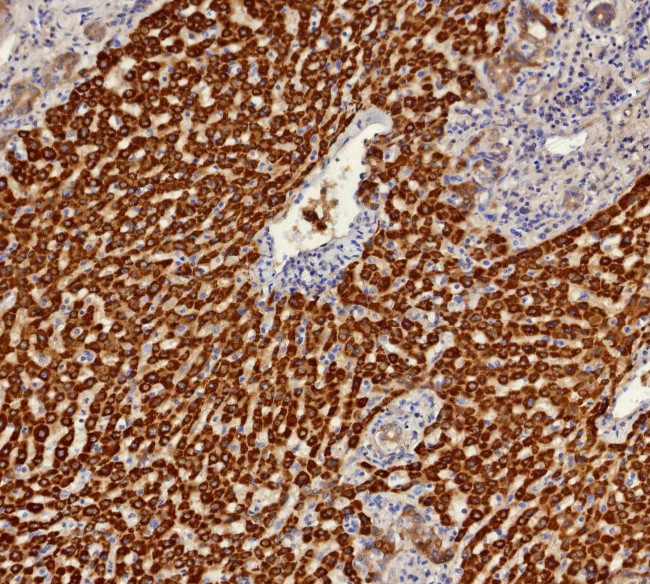
Aldo-keto Reductase Family 1 Member C1/DD1 Antibody in Immunohistochemistry (Paraffin) (IHC (P))

Search
NeoBiotechnologies
Aldo-keto Reductase Family 1 Member C1/DD1 Monoclonal Antibody (AKR1C1/9314)
{{$productOrderCtrl.translations['antibody.pdp.commerceCard.promotion.promotions']}}
{{$productOrderCtrl.translations['antibody.pdp.commerceCard.promotion.viewpromo']}}
{{$productOrderCtrl.translations['antibody.pdp.commerceCard.promotion.promocode']}}: {{promo.promoCode}} {{promo.promoTitle}} {{promo.promoDescription}}. {{$productOrderCtrl.translations['antibody.pdp.commerceCard.promotion.learnmore']}}
产品信息
1645-MSM11-P1ABX
种属反应
宿主/亚型
分类
类型
克隆号
抗原
偶联物
形式
浓度
规格
纯化类型
保存液
内含物
保存条件
运输条件
产品详细信息
Positive Control:Human liver or stomach tissue.
Cellular Location: Cytoplasm.
靶标信息
This gene encodes a member of the aldo/keto reductase superfamily, which consists of more than 40 known enzymes and proteins. These enzymes catalyze the conversion of aldehydes and ketones to their corresponding alcohols by utilizing NADH and/or NADPH as cofactors. The enzymes display overlapping but distinct substrate specificity. This enzyme catalyzes the reaction of progesterone to the inactive form 20-alpha-hydroxy-progesterone. This gene shares high sequence identity with three other gene members and is clustered with those three genes at chromosome 10p15-p14.
仅用于科研。不用于诊断过程。未经明确授权不得转售。
篇参考文献 (0)
生物信息学
蛋白别名: 20 alpha-hydroxysteroid dehydrogenase; 20-alpha-HSD; 20alpha-hydroxysteroid dehydrogenase; 3beta-hydroxysteroid 3-dehydrogenase; aldo-keto reductase C; Aldo-keto reductase family 1 member C1; chlordecone reductase homolog; Chlordecone reductase homolog HAKRC; DD1; Dihydrodiol dehydrogenase 1; dihydrodiol dehydrogenase 1/2; dihydrodiol dehydrogenase 1; 20-alpha (3-alpha)-hydroxysteroid dehydrogenase; HBAB; hepatic dihydrodiol dehydrogenase; High-affinity hepatic bile acid-binding protein; indanol dehydrogenase; oxidoreductase; RP11-69D4.1; trans-1,2-dihydrobenzene-1,2-diol dehydrogenase; type II 3-alpha-hydroxysteroid dehydrogenase; unnamed protein product
基因别名: 2-ALPHA-HSD; 20-ALPHA-HSD; AKR1C1; C9; DD1; DD1/DD2; DDH; DDH1; H-37; HAKRC; HBAB; MBAB
UniProt ID: (Human) Q04828
Entrez Gene ID: (Human) 1645